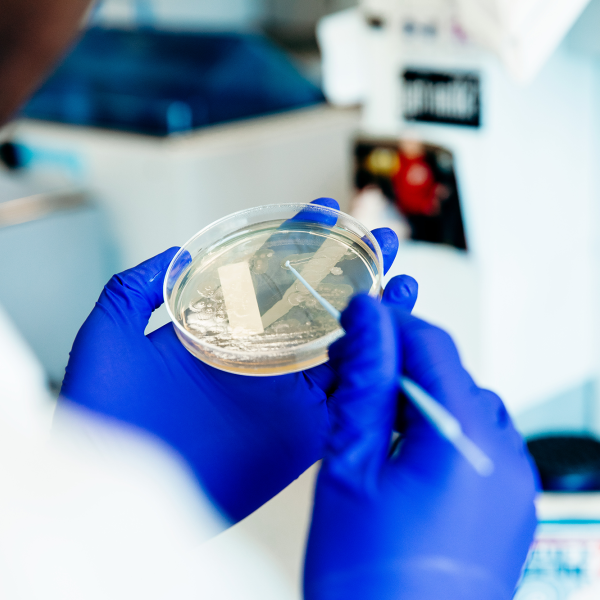
blue gloved hands hold a petri dish

New book confronts struggle between agribusiness and democracy in California
News
The book “ In the Struggle: Scholars and the Fight Against Industrial Agribusiness in California ” by Professor Scott J. Peters and Daniel J. O’Connell, Ph.D. ’11 weaves together the stories of eight scholar-activists who opposed agribusiness...